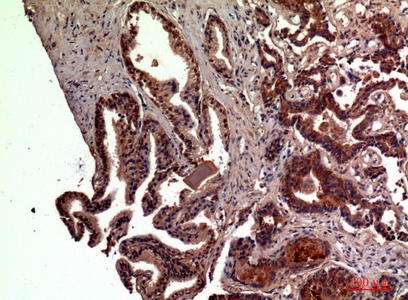
Fig.2. Immunohistochemical analysis of paraffin-embedded human-prostate-cancer, antibody was diluted at 1:100.

| Product name | RSAD2 Polyclonal Antibody |
| Immunogen | Synthesized peptide derived from the N-terminal region of human RSAD2 |
| Host | Rabbit |
| Reactivity | Human,Rat,Mouse, |
| Applications | WB,IHC,IF,ELISA |
| Applications notes | Optimal working dilutions should be determined experimentally by the investigator. Suggested starting dilutions are as follows: WB 1:500-1:2000;IHC: 1:100-1:300;ELISA 1:20000;IF 1:50-200 |
| Clonality | Polyclonal |
| Preparation method | The antibody was affinity-purified from rabbit antiserum by affinity-chromatography using epitope-specific immunogen. |
| Alternative | RSAD2; CIG5; Radical S-adenosyl methionine domain-containing protein 2; Cytomegalovirus-induced gene 5 protein; Viperin; Virus inhibitory protein, endoplasmic reticulum-associated, interferon-inducible |
| Formulation | Liquid solution |
| Concentration | 1 mg/ml |
| Molecular weight | 42kD |
| Storage buffer | Liquid in PBS containing 50% glycerol, 0.5% BSA and 0.02% sodium azide. |
| Storage instructions | Stable for one year at -20°C from date of shipment. For maximum recovery of product, centrifuge the original vial after thawing and prior to removing the cap. Aliquot to avoid repeated freezing and thawing. |
| Shipping | Gel pack with blue ice. |
| Precautions | The product listed herein is for research use only and is not intended for use in human or clinical diagnosis. Suggested applications of our products are not recommendations to use our products in violation of any patent or as a license. We cannot be responsible for patent infringements or other violations that may occur with the use of this product. |
| Background | RSAD2 (Radical S-Adenosyl Methionine Domain Containing 2) is a Protein Coding gene. Diseases associated with RSAD2 include influenza and encephalitis. Among its related pathways are Immune System and Interferon gamma signaling. Gene Ontology (GO) annotations related to this gene include protein self-association and iron-sulfur cluster binding. Interferon-inducible iron-sulfur (4FE-4S) cluster-binding antiviral protein which plays a major role in the cell antiviral state induced by type I and type II interferon. Can inhibit a wide range of DNA and RNA viruses, including human cytomegalovirus (HCMV), hepatitis C virus (HCV), west Nile virus (WNV), dengue virus, sindbis virus, influenza A virus, sendai virus, vesicular stomatitis virus (VSV), and human immunodeficiency virus (HIV-1). Displays antiviral activity against influenza A virus by inhibiting the budding of the virus from the plasma membrane by disturbing the lipid rafts. This is accomplished, at least in part, through binding and inhibition of the enzyme farnesyl diphospate synthase (FPPS), which is essential for the biosynthesis of isoprenoid-derived lipids. Promotes TLR7 and TLR9-dependent production of IFN-beta production in plasmacytoid dendritic cells (pDCs) by facilitating Lys-63-linked ubiquitination of IRAK1. Plays a role in CD4+ T-cells activation and differentiation. Facilitates T-cell receptor (TCR)-mediated GATA3 activation and optimal T-helper 2 (Th2) cytokine production by modulating NFKB1 and JUNB activities. Can inhibit secretion of soluble proteins. |
| Gene ID | 91543 |
| Alternative | RSAD2; CIG5; Radical S-adenosyl methionine domain-containing protein 2; Cytomegalovirus-induced gene 5 protein; Viperin; Virus inhibitory protein, endoplasmic reticulum-associated, interferon-inducible |
| Others | RSAD2 Polyclonal Antibody detects endogenous levels of RSAD2 protein. |
| Accession | Q8WXG1 |
| Observed Band(KD) | 42 |

Fig.1. Western Blot analysis of HepG2 cells using RSAD2 Polyclonal Antibody. Secondary antibody (catalog#: A21020) was diluted at 1:20000.
Fig.2. Immunohistochemical analysis of paraffin-embedded human-prostate-cancer, antibody was diluted at 1:100.

Fig.3. Immunohistochemical analysis of paraffin-embedded human-prostate-cancer, antibody was diluted at 1:100.

Fig.4. Immunohistochemical analysis of paraffin-embedded human-brain, antibody was diluted at 1:100.
You must be logged in to post a review.
Reviews
There are no reviews yet.